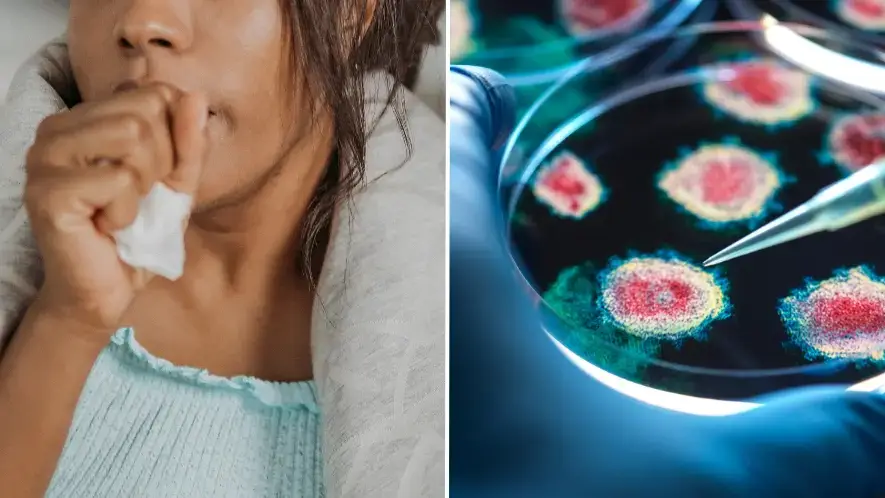
'Quad-demic' warning issued to Brits as cases of winter bugs surge across UK

A 'quad-demic' is wiping out Brits left, right and centre, according to the UK Health and Security Agency.
As such, medics and GPs up and down the country are telling us about the best means of protecting ourselves from four uber-contagious illnesses that are said to be doing the rounds - especially as the icy winter months continue to creep in.
Hospital visits, medication prescriptions and 111 calls sky-rocket during the coldest months of the year - usually on the build up to Christmas.
So, right about now.
Advert

The brisk weather and famously sociable season combine to push celebrants into warm, cramped indoor spaces - ideal environments for germs and bacteria to spread from person to person.
And just to make matters worse, this frosty time of year often makes it difficult for patients to get themselves to pharmacies and chemists to receive medication, with medical staff also low on the ground.
As a result, infections fester and spread, rather than get treated.
This year, however, it isn't just the common cold that we should be fearing, with UK GPs believing that a combination of four different ailments could be coming together to wipe out huge proportions of the population.
Well, not 'wipe out' in a deathly sense, but leave people seriously, seriously ill.

Dubbed a 'quad-demic', the UKHSA describe the four horsemen of the 2024 festive season as Covid-19, flu, respiratory syncytial virus (RSV) and norovirus (the 'vomiting bug').
According to statistic released by health body, the latter three conditions have triggered a colossal spike in numbers in the last week alone.
And earlier this year, the NHS previously declaring that most people infected with Coronavirus will experience 'mild to moderate respiratory illness' as Christmas approaches.
"[These are] four very common viral illnesses that circulate every winter in different peaks," NHS GP Dr Alexander Allen explained to Sky News.
"This is peak time so even if you are fit and healthy, your chances of catching all of these illnesses if quite high."
He added: "Flu is the cause of the rise in winter illnesses that we’ve seen in the past week, with emergency department attendances also increasing."

Asked how best to combat these conditions, he said a vaccinations are key - particularly in the cases Covid-19 and the flu.
Members of the over 65 community, as well as anyone with a health condition that makes them 'vulnerable', care home residents and front-line workers, can book in to receive a Covid-19 booster jab.
Even if you've not been contacted by the NHS, you can book your own appointment via the NHS app, GPs, pharmacies, or by calling 119.
When it comes to the flu vaccine, it is also free for every group previously mentioned, but also extends to pregnant women, carers for older or disabled people, and those living with people who have a weakened immune system.
Appointments for flu jabs can also be booked at a pharmacy, online or by using the NHS app.
RVS vaccines are particularly recommended this time of year for pregnant people, with the NHS claiming they can help protect babies after they're born.

Mothers-to-be will be contacted around 28 weeks into their term to receive the vaccine, which isn't recommended after this point.
Your maternity service or local GP should be able to offer the jab - which is also recommended for people aged between 75 to 79.
Sadly, there is no vaccine for norovirus.
Being that it is extremely contagious, however, the NHS says that anyone with symptoms should avoid contact with others for at least 48 hours.